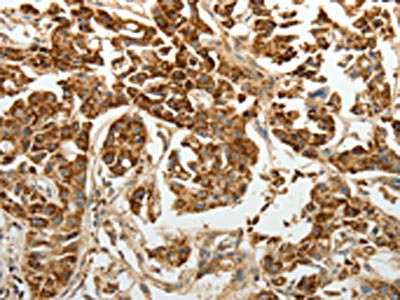

SELE Antibody
-
中文名稱:SELE兔多克隆抗體
-
貨號(hào):CSB-PA775739
-
規(guī)格:¥1100
-
圖片:
-
The image on the left is immunohistochemistry of paraffin-embedded Human esophagus cancer tissue using CSB-PA775739(SELE Antibody) at dilution 1/30, on the right is treated with fusion protein. (Original magnification: ×200)
-
The image on the left is immunohistochemistry of paraffin-embedded Human lung cancer tissue using CSB-PA775739(SELE Antibody) at dilution 1/30, on the right is treated with fusion protein. (Original magnification: ×200)
-
-
其他:
產(chǎn)品詳情
-
Uniprot No.:
-
基因名:
-
別名:SELE; ELAM1; E-selectin; CD62 antigen-like family member E; Endothelial leukocyte adhesion molecule 1; ELAM-1; Leukocyte-endothelial cell adhesion molecule 2; LECAM2; CD antigen CD62E
-
宿主:Rabbit
-
反應(yīng)種屬:Human
-
免疫原:Fusion protein of Human SELE
-
免疫原種屬:Homo sapiens (Human)
-
標(biāo)記方式:Non-conjugated
-
抗體亞型:IgG
-
純化方式:Antigen affinity purification
-
濃度:It differs from different batches. Please contact us to confirm it.
-
保存緩沖液:-20°C, pH7.4 PBS, 0.05% NaN3, 40% Glycerol
-
產(chǎn)品提供形式:Liquid
-
應(yīng)用范圍:ELISA,IHC
-
推薦稀釋比:
Application Recommended Dilution ELISA 1:2000-1:5000 IHC 1:50-1:200 -
Protocols:
-
儲(chǔ)存條件:Upon receipt, store at -20°C or -80°C. Avoid repeated freeze.
-
貨期:Basically, we can dispatch the products out in 1-3 working days after receiving your orders. Delivery time maybe differs from different purchasing way or location, please kindly consult your local distributors for specific delivery time.
-
用途:For Research Use Only. Not for use in diagnostic or therapeutic procedures.
相關(guān)產(chǎn)品
靶點(diǎn)詳情
-
功能:Cell-surface glycoprotein having a role in immunoadhesion. Mediates in the adhesion of blood neutrophils in cytokine-activated endothelium through interaction with SELPLG/PSGL1. May have a role in capillary morphogenesis.
-
基因功能參考文獻(xiàn):
- Results highlight novel mechanisms by which p38 downregulates the expression of E-selectin through miR-146a and miR-31 following inflammatory stimuli associated to cancer progression. PMID: 29402939
- Levels of E and P selectin showed positive correlation with the length of stay. PMID: 29517629
- Our study shows a significant association of E-selectin gene polymorphism(Leu554Phe) with essential hypertension. PMID: 29178542
- The highest levels of sL- and sE-selectin were observed in colorectal patients with lymph node metastasis. PMID: 27775438
- Circulating CD62E(+) microparticle levels are abnormal in subjects with pre-diabetes. PMID: 28927403
- sVCAM-1 reflects xerostomia in primary Sjogren's syndrome. sICAM-1 and sE-selectin may be additional parameters of secondary Sjogren's syndrome activity. PMID: 29068581
- Neutrophil rolling over E-selectin at precise shear stress transmits tension and catch-bond formation with L-selectin via sLe(x), resulting in focal clusters that deliver a distinct signal to upshift beta2-integrins to a high-affinity state. Rivipansel effectively blocked formation of selectin catch-bonds, revealing a novel mechanotransduction circuit PMID: 28811304
- E-selectin-dependent rolling promotes adhesion to HA by both physically slowing cells and enabling them to position proximal to the surface, thereby increasing the on rate of adhesion. PMID: 28765175
- High E-selectin expression is associated with breast cancer metastasis. PMID: 27220365
- his study shows that two adhesion molecules, shed as soluble forms, are elevated during the acute phase of leptospirosis: E-selectin and s-ICAM1. These molecules may interfere with the process of immune cell recruitment to clear Leptospira at tissue levels. PMID: 28686648
- ELAM-1 upregulation may promote disorder in adhesion, and migration of the cells leading to the endometriosis disorder. PMID: 27433816
- Elevated endothelium-related mediators (vWF, E-selectin and EPCR) appear to participate in the development of pancreatic necrosis and may be a potential indicator of overall prognosis. PMID: 28007459
- interplay between flow-dependent on-rate and off-rate of E-selectin-ligand bonds determine flow-enhanced cell rolling stability PMID: 27558713
- High SELE expression is associated with Inflamed Atherosclerotic Plaque. PMID: 27237221
- In this study, we addressed this question by analysing sLex expression together with two glycoproteins (BST-2 and LGALS3BP), shown to interact with E-selectin in a carbohydrate-dependent manner, in a cohort of 249 invasive breast cancers PMID: 27176937
- SELE expression is significantly upregulated in human masticatory mucosa during wound healing PMID: 28005267
- E-selectin concentrations in this study were associated with hyperglycemia, possibly reflecting early endothelial damage. E-selectin was not useful to assess carotid intima-media thickness, a marker of subclinical atherosclerosis, which appeared to be determined by aging and male gender. PMID: 27141013
- Plasma E-selectin is overexpressed in pediatric patients with mycoplasma pneumoniae pneumonia and myocardial injury. PMID: 26843511
- The significant presence of CLA+ T cells and E-selectin (CD62E) expressions in the OLPG suggests their involvement in the etiopathogenesis of oral lichen planus ; however, only a weak correlation between CLA+ T cells and E-selectin was observed. PMID: 26332489
- BD patients have a lower expression of ICAM-1, VCAM-1, and E-selectin in their tumor tissues. BD-HDL facilitates the adhesion of tumor cells to vascular endothelium by upregulating the expression of ICAM-1 and VCAM-1, thereby promoting the initial progression of breast cancer metastasis PMID: 26872904
- The E-selectin S149R polymorphisms is associated with the oncogenesis of breast cancer. PMID: 26828984
- Neisseria meningitidis caused a high level of E-selectin expression elicited by the activity of phosphorylated ATF2 transcription factor on the E-selectin promoter. PMID: 26153406
- E-selectin is more effective than cTnI in diagnosing myocardial injury in children. PMID: 26617843
- Inhibition of E-selectin expression allows an anti-tumoral effect on sLex-expressing hepatocellular carcinoma tumors in vivo PMID: 26988221
- Glycosphingolipids likely contribute to human myeloid cell adhesion to E-selectin under fluid shear, particularly the transition of rolling cells to firm arrest. PMID: 26868209
- Data show that both mucin16 (MUC16) and podocalyxin (PODXL)-E-selectin-mediated interactions are mechanically stronger than like L-selectin interactions at the single-molecule level. PMID: 26329844
- These findings provide consistent evidence that A516C and G98T polymorphisms of the SELE gene may be associated with increased susceptibility of coronary artery disease. PMID: 26937892
- Glaucomatous MYOC mutations activate the IL-1beta/NF-kappaB inflammatory stress response and the glaucoma marker SELE in trabecular meshwork cells. PMID: 26396484
- P. gingivalis was shown to activate NOD1, NOD2, and TLR2 expression, resulting in increased E-selectin expression in endothelial cells; direct inhibition of NF-kappaB and P38 MAPK significantly attenuated E-selectin expression induced by P. gingivalis in endothelial cells PMID: 25939768
- The number of E-selectin-positive cells was significantly higher in the tuberculoid form than in the lepromatous form of leprosy skin lesions. PMID: 26051909
- Gene-based study revealed significant associations of the SELE gene with Blood Pressure phenotypes for the first time among the Chinese Han population. PMID: 25424718
- This study showed that no significant differences in F206L Polymorphism of l-Selectin Between the Patients with Bronchial Asthma and Control. PMID: 24798295
- Blood ESEL was higher in pregnant women with preeclampsia, and non-pregnant women with a history of preeclampsia than women without preeclampsia or a history of preeclampsia. PMID: 26116870
- The findings suggest that C allele carriers of the SELE gene polymorphism (A561C) might be predisposed to EH in the Chinese population. PMID: 25171839
- E-selectin promoter was highly and specifically acetylated in the confluent monolayer after tumor necrosis factor alpha activation. PMID: 24690766
- E-selectin interactions with glycoprotein ligands (CD44/hematopoietic cell E-/L-selectin ligand and PSGL-1) mediate the initial capturing of cells out of flow. PMID: 26124272
- SELE rs3917412 and MTHFR rs1801133 SNPs could serve as pharmacogenetic predictors of tumor recurrence in patients with early-stage colon cancer treated with oxaliplatin-based adjuvant chemotherapy PMID: 24980946
- sE-selectin and the LDL were the most important predictors of late arteriovenous fistula stenosis PMID: 24627030
- The C allele of E-selectin A561C gene polymorphism might increase the essential hypertension (EH) risk in Asian population, whereas the T allele of E-selectin C1839T gene polymorphism might decrease the EH risk. [meta-analysis] PMID: 25003340
- Bereaved respondents had higher levels of inflammatory biomarkers IL-6 and sE-selectin, but not CRP and sICAM-I than the non-bereaved. PMID: 24266503
- SE-selectin and PAPPA may contribute to future cardiovascular events in women post preeclampsia; in contrast, ApoB may be involved in a protective mechanism PMID: 25238218
- the haplotype TCC in the Han hypertensive patients and the haplotype GGC in the Mongolian patients had independent effects in increasing the risk for essential hypertension; multiple single-nucleotide polymorphisms in combination in SELE may confer a risk of hypertension. PMID: 25748737
- Found the AC genotype to be a significant risk factor for hemorrhagic stroke and we also found significant differences in AC genotype and C allele among hemorrhagic stroke and ischemic stroke patients. PMID: 25168603
- The rs5361 E-selectin gene polymorphism is not a susceptibility marker for ACS in Western Mexico population. However, sE-selectin may be a biological marker of ACS. PMID: 25147432
- ST3Gal-4 is the primary sialyltransferase regulating the synthesis of E-, P-, and L-selectin ligands on human myeloid leukocytes PMID: 25498912
- an upregulation of E-selectin and the associated influx of neutrophils may play a significant role in the resolution of inflammation as well as for the pathophysiology of nasal polyps of Caucasian chronic rhinosinusitis patients. PMID: 24995349
- in human aortic and vein endothelial cells, expression and release of ICAM-1 and E-selectin were induced by treatment with conditioned medium collected from Pal-stimulated pTHP-1 cells PMID: 25201247
- CD62E was found to be a new biomarker for patients with hypertension and hyperlipidemia. PMID: 24820735
- High E-Selectin expression is associated with small cell lung cancer metastasis. PMID: 24699516
- there was association between the E-selectin S128R polymorphism and the risk of cancer. PMID: 24815478
顯示更多
收起更多
-
亞細(xì)胞定位:Cell membrane; Single-pass type I membrane protein.
-
蛋白家族:Selectin/LECAM family
-
數(shù)據(jù)庫(kù)鏈接:
Most popular with customers
-
YWHAB Recombinant Monoclonal Antibody
Applications: ELISA, WB, IHC, IF, FC
Species Reactivity: Human, Mouse, Rat
-
Phospho-YAP1 (S127) Recombinant Monoclonal Antibody
Applications: ELISA, WB, IHC
Species Reactivity: Human
-
-
-
-
-
-